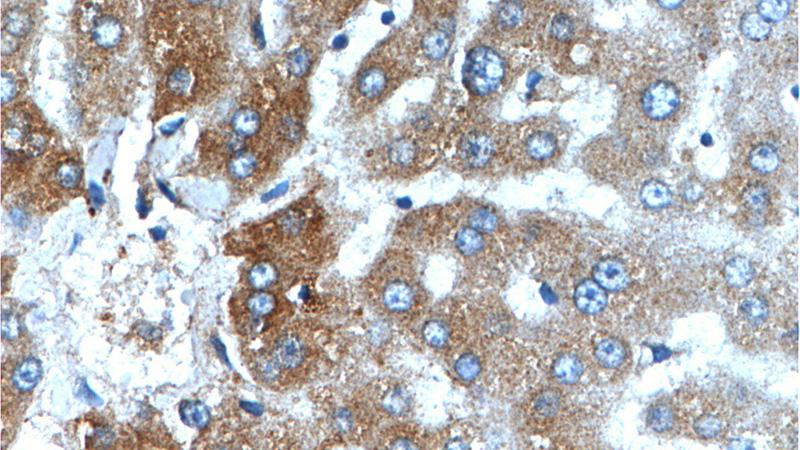
Immunohistochemistry of paraffin-embedded human liver tissue slide using Catalog No:109684(CYP1A2-Specific Antibody) at dilution of 1:200 (under 40x lens).

-
Product Name
CYP1A2-Specific antibody
- Documents
-
Description
CYP1A2-Specific Rabbit Polyclonal antibody. Positive WB detected in mouse liver tissue. Positive IP detected in mouse liver tissue. Positive IHC detected in human liver tissue. Positive IF detected in Hela cells. Positive FC detected in HeLa cells. Observed molecular weight by Western-blot: 58 kDa
-
Tested applications
ELISA, WB, IF, FC, IP, IHC
-
Species reactivity
Human,Mouse,Rat; other species not tested.
-
Alternative names
CP12 antibody; CP1A2 antibody; CYP1A2 antibody; CYPIA2 antibody; CytOChrome P(3)450 antibody; CytOChrome P450 1A2 antibody; CytOChrome P450 4 antibody; CytOChrome P450 P3 antibody; P3 450 antibody; P450(PA) antibody
-
Isotype
Rabbit IgG
-
Preparation
This antibody was obtained by immunization of Peptide (Accession Number: NM_000761). Purification method: Antigen affinity purified.
-
Clonality
Polyclonal
-
Formulation
PBS with 0.02% sodium azide and 50% glycerol pH 7.3.
-
Storage instructions
Store at -20℃. DO NOT ALIQUOT
-
Applications
Recommended Dilution:
WB: 1:500-1:5000
IP: 1:200-1:1000
IHC: 1:20-1:200
IF: 1:10-1:100
-
Validations

mouse liver tissue were subjected to SDS PAGE followed by western blot with Catalog No:109684(CYP1A2-Specific antibody) at dilution of 1:1000

Immunofluorescent analysis of Hela cells, using CYP1A2 antibody Catalog No:109684 at 1:25 dilution and Rhodamine-labeled goat anti-rabbit IgG (red).

IP Result of anti-CYP1A2-Specific (IP:Catalog No:109684, 4ug; Detection:Catalog No:109684 1:300) with mouse liver tissue lysate 4000ug.
Immunohistochemistry of paraffin-embedded human liver tissue slide using Catalog No:109684(CYP1A2-Specific Antibody) at dilution of 1:200 (under 40x lens).

1X10^6 HeLa cells were stained with .5ug CYP1A2-Specific antibody (Catalog No:109684, red) and control antibody (blue). Fixed with 4% PFA blocked with 3% BSA (30 min). FITC-Goat anti-Rabbit IgG with dilution 1:100.
-
Background
CYP1A2, also named as CP12; P3-450 and P450(PA), belongs to the cytochrome P450 family. Cytochromes P450 are a group of heme-thiolate monooxygenases. In liver microsomes, CYP1A2 is involved in an NADPH-dependent electron transport pathway. It oxidizes a variety of structurally unrelated compounds, including steroids, fatty acids, and xenobiotics. Most active of CYP1A2 is in catalyzing 2-hydroxylation. Caffeine is metabolized primarily by cytochrome CYP1A2 in the liver through an initial N3-demethylation. It also acts in the metabolism of aflatoxin B1 and acetaminophen. CYP1A2 participates in the bioactivation of carcinogenic aromatic and heterocyclic amines. It catalizes the reaction: RH + reduced flavoprotein + O2 = ROH + oxidized flavoprotein + H2O. The antibody is specific to CYP1A2.
-
References
- Moriya N, Kataoka H, Fujino H, Nishikawa J, Kugawa F. Different expression patterns of hepatic cytochrome P450 s during anaphylactic or lipopolysaccharide-induced inflammation. Die Pharmazie. 69(2):142-7. 2014.
- Lv L, Han Q, Chu Y. Self-renewal of hepatoblasts under chemically defined conditions by iterative growth factor and chemical screening. Hepatology (Baltimore, Md.). 61(1):337-47. 2015.
Related Products / Services
Please note: All products are "FOR RESEARCH USE ONLY AND ARE NOT INTENDED FOR DIAGNOSTIC OR THERAPEUTIC USE"
